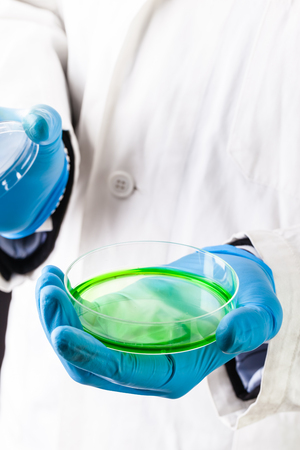
a doctor or researcher with a white lab coat holding a petri dish filled with green gooの写真素材

写真素材 - a doctor or researcher with a white lab coat holding a petri dish filled with green goo
作品情報
a doctor or researcher with a white lab coat holding a petri dish filled with green goo
- ID:60367936
- 作品種別:写真
- 作者名:Dario Lo Presti
キーワード
- Industry
- Medicine
- Plate
- agar
- analysis
- bacteria
- bacterium
- biochemistry
- biological
- biology
- biotechnology
- chemist
- chemistry
- clinical
- closeup
- colony
- culture
- danger
- dish
- equipment
- experiment
- germs
- gloves
- green
- growth
- hand
- holding
- imunology
- infection
- lab
- laboratory
- medical
- microbiologist
- microbiology
- organism
- petri
- pharmaceutical
- professional
- protective
- research
- researcher
- researching
- sample
- science
- scientific
- scientist
- test
- virus
- weapon
類似作品
Senior woman, s...
Doctor in blue ...
Health care res...
Woman researche...
Lab practitione...
biochemical res...
Doctor with syr...
An Asian male s...
Lab technician ...
Young woman sci...
scientist worki...
Male Scientist ...
young 8 yo boy ...
Medical researc...
Lab practitione...
Researcher usin...
Bioarcheology. ...
Scientist using...
Chemists in a l...
Research, exper...
biochemical res...
Microscope near...
A scientist in ...
biochemical res...
Portrait of cau...
Male specialist...
Scientist pipet...
Scientist holdi...
Doctor in a pro...
Male scientist ...
A researcher is...
professional ch...
Laboratory test...
Lab assistant, ...
scientist worki...
Portrait of a ...
A dedicated sci...
Young chemist s...
Exhausted stres...
Scientist afric...
scientist worki...
Asian Doctor or...
Young laborator...
Female research...
Scientist adjus...
Researchers wor...
Close-up of a m...
Forensic Scienc...
Chemist mixing ...